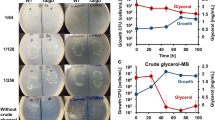

Abstract
PREVIOUS attempts at studying the antigens of Azotobacter have met with only limited success. Azo and Yoshida in a brief report1 described complement-fixation by Azotobacter cells in the presence of specific antisera but gave few experimental details. Jensen and Petersen2 obtained an agglutinating antiserum for Azotobacter chroococcum. Recently, Petersen3 studied the agglutinogens of Az. chroococcum, Az. vinelandii, and Az. agilis. Az. chroococcum and Az. vinelandii had antigens in common and showed serological affinities to Beijerinckia sp. Az. agilis appeared to be antigenically distinct. Eisenstark et al., on the other hand, using apparently adequate technical methods, failed to produce antisera to Az. agilis or “numerous other azotobacter species”. Heidelberger (quoted in Lawson and Stacey5) showed Az. chroococcum polysaccharide to be antigenic.
This is a preview of subscription content, access via your institution
Access options
Subscribe to this journal
Receive 51 print issues and online access
$199.00 per year
only $3.90 per issue
Buy this article
- Purchase on SpringerLink
- Instant access to the full article PDF.
USD 39.95
Prices may be subject to local taxes which are calculated during checkout
Similar content being viewed by others
References
Azo, K., and Yoshida, R., Proc. First Int. Congr. Soil Sci., 3, 150 (1928).
Jensen, V., and Petersen, E. J., Roy. Vet. and Agric. Coll., Copenhagen, Den., Yearbook, 107 (1955).
Petersen, E. J., Roy. Vet. and Agric. Coll., Copenhagen, Den., Yearbook, 70 (1959).
Eisenstark, A., Ward, C. B., and Kyle, T. S., J. Bact., 60, 525 (1950).
Lawson, G. J., and Stacey, M., J. Chem. Soc., 1925 (1954).
Carr, L. B., and Varner, J. E., Bact. Proc., 53 (1958).
Jensen, V., Bot. Tidsskr., 52, 143 (1955).
Johnstone, D. B., App. Microbiol., 5, 103 (1957).
Author information
Authors and Affiliations
Rights and permissions
About this article
Cite this article
NORRIS, J. Antigens of Azotobacter . Nature 185, 634–635 (1960). https://doi.org/10.1038/185634a0
Issue date:
DOI: https://doi.org/10.1038/185634a0
This article is cited by
-
TheAzotobacter flora of some Czechoslovakian watercourses
Folia Microbiologica (1975)